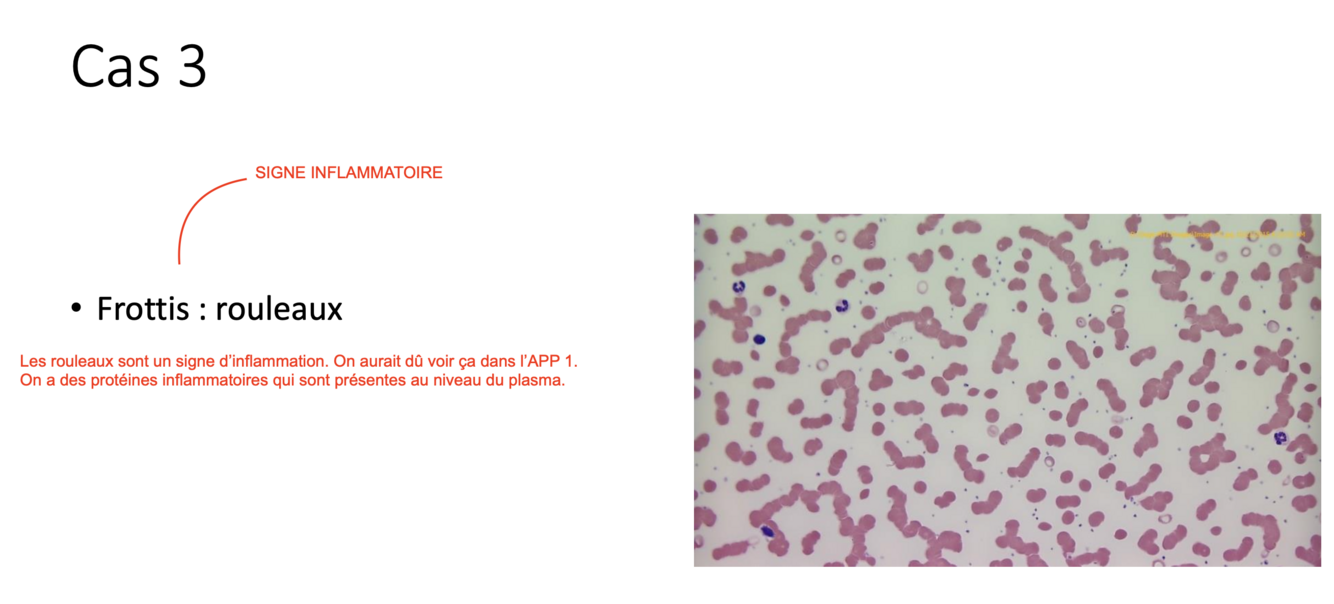

Jeune femme de 25 ans, végétarienne. Anémie de novo depuis 6 mois. Histoire de prise d’AINS pour douleurs menstruelles
Symptômes :
- Fatigabilité, Palpitations, dyspnée d’effort.
- Menstruations abondantes
Signes :
- Pâle, tachycarde.
- Chéilite angulaire
Question 1
- Quelle est votre interprétation des différents indices de la FSC et quel est votre diagnostic différentiel ?
Question 2
- Quels en sont vos éléments de réflexions pertinents de l’histoire clinique ?
Question 3
- Que demanderiez-vous comme analyse pour compléter le bilan et préciser la signification de ces tests (ex: fer sérique, capacité de liaison etc.) ?

Question 1 :
- Anémie microcytaire hypochrome avec DVE augmentée. Considérant l’histoire clinique, le premier diagnostic différentiel serait l’anémie ferriprive. (Or, avec un VGM bas, ça pourrait quand même être autre chose, comme thalassémie, anémie sidéroblastique ou intoxication au plomb, mais l’histoire nous indique le plus vers l’anémie ferriprive)
Question 2 :
- Symptômes généraux de l’anémie : fatigabilité, palpitations, dyspnée à l’effort, tachychardie, pâle.
- Symptômes spécifiques à l’anémie ferriprive : chélite angulaire.
- Diète végétarienne = manque d’apport en fer.
- Menstruations abondantes = pertes de fer.
- AINS = saignements digestifs possibles = pertes de fer.
Question 3 :
- Un bilan martial pour confirmer notre diagnostic.
Femme de 17 ans, d’origine haïtienne, arrivée au Canada peu après sa naissance. Traitée avec du fer depuis 3 ans. Histoire familiale d’anémie.
Se plaint d’une légère fatigue.
Aucun signe pertinent à l’examen physique.
Les résultats du bilan de fer sont les suivants:
- Fer sérique : normal.
- TIBC : normal.
- % de saturation : normale.
- Ferritine : normale.
Question 1 :
- Quel serait votre diagnostic principal ?
Question 2 :
- Quel(s) test(s) complémentaire(s) recommanderiez-vous pour confirmer votre diagnostic ?

Question 1 :
- Probablement une thalassémie : ATCD familiaux, haïtienne, bilan martial normal, VGM très bas p/r au niveau d’anémie, DVE normal (car tous les GR sont modifiés de la même façon).
Question 2 :
- Électrophorèse de l’hémoglobine : on veut confirmer la thalassémie et son type (alpha ou bêta).
- Beta thalassémie : augmentation de l’hémoglobine A2 à l’électrophorèse de l’hémoglobine (peut être manquée/absente si anémie ferriprive concomitante)
- Alpha thalassémie : électrophorèse normale… Au besoin, on peut chercher les mutations génétiques. Aussi, on aurait probablement une splénomégalie.
- Dans certaines situations plus complexes, on peut demander une étude familiale – les mutations sont transmises par les parents
Femme de 65 ans ayant une arthrite rhumatoïde active depuis 5 ans avec nombreuses déformations articulaires et raideur matinale +++.
- Rx : Anti-inflammatoire (AINS).
Revue des systèmes :
- pas de mélena.
- pas de rectorragie.
- ou autre site de spoliation.
Examen physique:
- pouls 80/min., TA: 120/80.
- pâle, anictérique.
- Poumons : murmure vésiculaire normal et symétrique.
- Cœur :B1 B2 N, pas de B4 ni B3.
- Abdomen : N.
- multiples nodules rhumatoïdes.
- déformations articulaires +++
Bilan martial :
- Fer sérique : bas.
- TIBC : bas.
- % de saturation : bas.
- Ferritine : normale
Autres éléments :
- Facteur rhumatoïde : +++.
Question 1
- Quelle est la cause probable de cette anémie ainsi que les diagnostics différentiels ?
Question 2 :
- Pourquoi les plaquettes sont élevées?

Question 1 :
- Anémie inflammatoire des maladies chroniques : plaquettes augmentent (caractéristique des inflammations), historique d’arthrite rhumatoïde, pas de saignements, ROULEAUX AU FROTTIS.
- Pas anémie ferriprive : ferritine normale.
- Pas thalassémie : modifications du bilan martial après tout.
Question 2 :
- C’est une thrombocytose inflammatoire (typique) (la déficience en fer aussi peut faire augmenter les plaquettes, mais pas le plus important ici).
Physiopathologie d’une inflammation :
- Diminution fabrication EPO.
- Diminution réponse EPO.
- Blocage utilisation fer intramedullaire à cause de l’augmentation de l’hepcidine.
Femme de 53 ans avec un diabète insulino-dépendant de longue date, traité avec insuline s/c.
- Rétinopathie diabétique, traité avec laser à deux reprises.
- Insuffisance artérielle des membres inférieurs et claudication intermittente.
- Asthénie progressive et dyspnée III/IV avec orthopnée à 2 oreillers.
Examen physique:
- Pouls 110/min., TA: 190/105.
- Teint grisâtre, oedématiée.
- Fundi: exsudats, hémorragies.
- Jugulaires distendues à 450.
- Poumons : crépitants ++; matités déclives.
- Cœur : bruits lointains ;frottement.
- Abdomen : Foie un peu augmenté.
- Extrémités : œdème ++++ ; pouls distaux absents
Question 1
- Établissez votre diagnostic différentiel.
Question 2
- Quelles analyses complémentaires suggérez-vous pour préciser votre diagnostic ?
Question 3
- Décrivez les facteurs ou mécanismes physiopathologiques pouvant contribuer à ce type d’anémie.

Question 1 :
- Anémie normochrome normocytaire.
- Légère neutrophilie.
- Réticulopénie. Est-ce qu’on a une atteinte de la moelle osseuse? Non, plaquettes et leucocytes normaux. C’est vraiment un problème de GR seulement.
- Poikilocytose = plusieurs formes de GR.
- Echynocytes et kératocytes = maladies métaboliques (foie ou rein).
- Vitesse de sédimentation augmentée = suggère un état inflammatoire.
- Diagnostic final : insuffisance rénael, qui diminuerait la production d’EPO, et inflammation des poumons.
Question 2 : Investigations complémentaires :
- Créatinine pour voir si c’est vrm un problème de rein.
- Dosage EPO.
- Radiographie pulmonaire : juste pour s’assurer que ce n’est pas une pneumonie ou un état inflammatoire quelconque des poumons.
- Bilan inflammatoire : martial.
Question 3 :
- Hémodilution.
- Déficits nutritionnels secondaire à la malabsorption entrainée par oedème muqueuse intestinale.
- Rôle des medicaments (si prenait un anticoagulant avec possibilité de saignement digestif secondaire; certains medicaments antihypertenseurs pourraient inhiber l’EPO).
Homme de 62 ans avec une histoire d’hypertension artérielle de longue date. Il prenait jusqu’à récemment de l’hydrochlorothiazide comme traitement.
- Suite à une rencontre intime imprudente, il a été nécessaire de lui prescrire de la pénicilline à haute dose.
- Trois semaines plus tard, lors d’une visite de contrôle, il dit avoir une fatigue accrue avec dyspnée II/IV, palpitations et angine de poitrine possible à l’effort.
Examen physique:
- Pouls 90/min., TA: 160/95.
- Ictère conjonctival discret.
- Jugulaires non distendues.
- Poumons : crépitants aux bases.
- Cœur : B1 diminué, B2 augmenté, B4 +, B3 +.
- Abdomen : pas d’hépatomégalie pas de splénomégalie.
- Extrémités : œdème +.
Question 1 :
- Y a-t-il anémie, et si oui, de quelle sorte?
Question 2 :
- Qu’est-ce qu’un sphérocyte ? Pourquoi y a-t-il augmentation du taux de réticulocytes ?
Question 3 :
- Établissez votre bilan complémentaire en précisant la signification des tests.

Question 1 :
- Oui, probablement une anémie hémolytique.
- Très légèrement macrocytaire.
- Réticulocytes augmentés et bleutés (donc problème périphérique : production médullaire adéquate).
- Présence de sphérocytes.
- Reçu de la pénicilline récemment.
- Léger ictère.
Question 2 :
- Sphérocyte = GR sphérique, car il a perdu une partie de sa membrane. Aurait pu être un défaut intrinsèque (hériditaire), mais comme notre patient est assez vieux ce n’est pas le cas ici. C’est donc extrinsèque : auto-immun, allo-immun (mère-bébé), brûlures, troubles électrolytiques ou médicaments.
- Les réticulocytes augmentent comme mécanisme compensatoire, car les GR n’amène plus autant d’oxygène aux organes, ce qui déclenche une sécrétion accrue d’EPO et augment l’erythropoïèse.
Question 3 :
- Bilan hémolyse : Bilirubine NC (augmentée), LDH (augmentée), Haptoglobine (diminuée), Test de Coombs (si positif, supporte le diagnostic d’une anémie auto-immune en identifiant anticorps à la surface du GR).
- Si lien avec médicament : arrêt du médicament.
- Dans ce cas : considérer une transfusion (Hb < 70 + risque d’infarctus), surtout considérant qu’il fait de l’angine et que son apport en oxygène est diminué (on ne voudrait pas que ça évolue en infarctus).
Quel est le diagnostic différentiel des anémies hémolytiques ?

Un homme de 47 ans se présente à l’urgence pour atteinte de l’état général. Il est peintre de maison à son compte.
Il dit être incapable de graver son escabeau depuis quelques jours pour cause d’essoufflement. Par ailleurs, il note que c’est comme s’il « marche sur du coton ouaté ».
À l’examen, il est pâle, tachycarde mais sans détresse. On note une langue lisse à l’examen physique ainsi qu’une disparition du sens vibratoire en-dessous des genoux bilatéralement.
Question 1 :
- Que pensez-vous de sa FSC ?
Question 2:
- Quel serait votre bilan complémentaire ?

Question 1 :
- Hb = basse. Plaquettes = N. GB = N.
- Macrocytaire +++.
- Neutrophiles hypersegmentés : mégaloblastique.
- Probablement un déficit en vit. B12 dû à l’anémie macrocytaire mégaloblastique et aux atteints des nerfs (comme marcher sur des cotons ouatés).
Question 2 :
- Vitamine B12.
- Folate (pour être sûr).
- Bilan hémolyse (car parfois réticulocytose augmente aussi VGM).
- Moelle si ambiguë.

Un homme de 65 ans se présente à l’urgence pour dyspnée et douleurs thoraciques.
- À l’examen, il est pâle, tachypnéïque et son pouls est à 120/min. Les membres inférieurs sont couverts de lésions suggestives d’un purpura. Il n’y a pas de splénomégalie ou d’hépatomégalie. Il a finalement de nombreux ulcères sur la paroi buccale.
- Le cardiologue vous indique que le patient est en voie de faire un infarctus du myocarde.
Selon le résultat de la formule sanguine qui suit :
Question 1 :
- Quelles seraient vos hypothèses ?
Question 2 :
- Quelles épreuves diagnostiques allez-vous demander ?
Question 3 :
- Doit-on procéder à une transfusion ?

Question 1 :
- On a une pancytopénie, donc deux options : (1) Problème central : moelle riche (hématopoïèse inefficace par déficience en B12 ou folates, remplacement par ¢ néoplasiques dans une leucémie, syndrome myélodysplasique (le fameux paradoxe)) ou moelle pauvre (aplasie méduallaire). (2) Destruction périphérique : hypersplénisme.
- Les dacryocytes suggèrent une infiltration de la moelle osseuse.
- Blastes en périphérie (anormal)”
- Probablement une leucémie ou SMD.
Question 2 :
- Aspiration et biopsie de la moelle osseuse.
- S’assurer de l’absence de complication immédiates.
Question 3 :
- Oui on devrait procéder à une transfusion de culot globulaire, car on ne va pas laisser le pt mourrir de son infarctus du myocarde.
- Une fois que c’est fait, on peut commencer à traiter l’infection et le problème hématologique.
Une jeune femme de 24 ans vous montre une FSC faite lors du bilan pré-emploi.
Elle se dit totalement asymptomatique.
À l’examen vous identifiez une splénomégalie à 3 cm sous le rebord costal.
Frottis sanguin : myélémie étagée.
Question 1 Quel est le diagnostic le plus probable ?
Question 2 Quelles épreuves complémentaires seraient utiles ?

Question 1 : myélémie étagée est typiquement associée à LMC. Neutrophilie est élevée mais pas de symptômes ni d’autres étiologies possible qu’une néoplasie. Basophiles augmentés et éosinophiles augmentés = sketch aussi. Splénomégalie nous oriente vers LMC.
Question 2 :
- FISH : pour t(9:22).
- Aspiration et biopsie de moelle est la plus importante : pour voir si les anomalies dans nos chromosomes orientent vrm vers LMC.
- Biologie moléculaire.
- GUIDES IMPORTANTS POUR DÉFINIR UN TRAITEMENT SPÉCIFIQUE.
LMC peut générer une LMA. Mais comme dans LMC on a une ¢ pluripotente qui prolifère, la LMC peut également générer une leucémie lymphoblastique aiguë (LLA), mais moins fréquent.

Femme de 22 ans en bonne santé jusqu’à tout récemment.
Depuis 2 jours, apparition de purpura, aux membres, au tronc associé à des ménorragies légères. Fatigue ++, fièvre à 38.3 degrés Celcius.
Toux avec douleurs thoraciques gauches depuis quelques jours.
Examen physique
Moche, apparence toxique
Pouls 120/min., TA: 100/65
T: 39 degrés Celcius
pétéchies +++, surtout aux membres inférieurs
Hyperplasie gingivale
Poumons: matité base gauche avec souffle tubaire
Pas d’hépatomégalie
Petite pointe de rate
Frottis sanguin : rouleaux et bâtonnets d’Auer.
Question 1 Quel est le diagnostic ?
Question 2 Quels tests additionnels demanderiez-vous ?

Question 1 :
- Neutros sont dans les valeurs normales, mais basses. Éosinophiles sont augmentées et surtout les monocytes. Et 90% de blastes. Hb basse, VGM normal, mais PLT sont ULTRA basses (à 10). Vitesse de sédimentation (marqueur inflammatoire) légèrement augmentée.
- Augmentation des éosinophiles n’est pas dû à une allergie, nouveaux mdx, retour de voyage qui aurait exposé aux parasites, donc probablement néoplasique.
- Anémie et thrombopénie oriente vrm plus vers leucémie aiguë.
- Blastes qui contiennent des bâtonnets d’Auer = leucémie myéloïde aiguë.
- Diagnostic : leucémie myéloïde aiguë (LMA).
Question 2 :
- Voir image ci-dessous.
*Avec trop de blastes qui sont énormes, ça peut nous donner de la leucostase, et ça nous donnes des symptômes qui ressemblent à des ischémies. Cette pte avait mal aux os qui ont davantage de moelle osseuse. *

Homme de 64 ans se présente à votre bureau pour : légère fatigabilité
Il aurait noté l’apparition de petites masses dans le cou et les aisselles depuis 6 mois.
Examen physique
Vous confirmez la présence des adénopathies de 1-2 cm au niveau cervicaux, sus-claviculaires, axillaires.
Vous palpez une rate évaluée à 4 cm sous le rebord costal gauche.
Frottis sanguin : Cellules lysés ++ Anysocytose +.
Question 1 Quelles sont vos hypothèses diagnostiques en tenant compte de l’histoire, l’examen et de la FSC ?
Question 2 Quels tests additionnels demanderiez-vous afin de confirmer le diagnostic ?
Question 3 Quel est le stade de la maladie?

Question 1 :
- Pas de blastes (donc plus chronique que aiguë). Lymphocytes vrm augmentés. Pas de cytopénies. Pas de gencives (LMA) ou de testicules infiltrées (LLA). Symptômes sont là depuis longtemps. Certes les basophiles sont hauts, mais le plus significatif est que les lympho sont ULTRA élevés.
- On s’oriente vers une forme de Lymphome Non-Hodgkinien (l’équivalent d’une LLC). Souvent indolents. Traitement « watch and wait ».
Question 2 :
- (pour le diagnostic) Cytométrie de flux sur les lymphocytes du sang : CD5 (typiquement LLC).
- (pour le pronostic) Analyses de cytogénétique et biologie moléculaire.
Question 3 :
- Stade II de Rai : splénomégalie + adénopathie + leucocytose significative.

Bambin de 7 ans arrive en ambulance à l’urgence en douleur abdominale aiguë avec température à 39 degrés Celcius.
À l’examen physique, il y a un abdomen aigu avec ressaut à la fosse iliaque droite (douleur).
Sa FSC est jointe.
Frottis sanguin : Granulations toxiques ++ Vacuoles ++
Corps de Döhle ++ Anysocytose +
Question 1 Quelle est le diagnostic le plus probable ?

Question 1 :
- On a une leucocytose caractérisée par augmentation de neutrophiles. Présence de stabs (¢ anormales).
- Légère anémie, augmentation de PLT et un peu de réticulocytes augmentés.
- Vacuoles, corps de Döhle et granulations toxiques nous oriente clairement vers une infection.
- Pas de blastes.
- Infection sévère peut faire des stabs (qui sont l’équivalent de bands). Ce n’est pas anormal non plus.
- Diagnostic principal : appendicite (thrombocytose est inflammatoire et l’anémie aussi).
Un homme de 73 ans, qui n’a pas d’antécédents médicaux ou chirurgicaux, vous consulte pour un prurit rebelle. Il est exaspéré. Depuis environ un an, il accuse une sensation de picotement qui a progressé pour devenir presque continu. Il a changé de type de savon pour le corps et de type de savon à lessive et a même changé les types de vêtements qu’il portait sans succès. Il remarque que ce prurit est beaucoup plus important après avoir pris une douche. Par ailleurs, il est peu symptomatique mais a des céphalées intermittentes, qu’il attribue à son manque de sommeil causé par le prurit et il a noté que sa vue a baissé légèrement depuis un an.
À l’examen, on note qu’il a un faciès pléthorique (très rouge) et qu’il a d’innombrables lésions de grattage sur la peau.
L’examen cardiaque et pulmonaire est normal. A l’examen de l’abdomen, on note une rate augmentée de volume à 5 cm sous le rebord costal.
Frottis sanguin : Microcytose + Polyglobulie + (bcp de GR).
Après avoir consulté la formule sanguine ci-jointe :
Question 1 Quel est votre diagnostic le plus probable?
Question 2 Quels examens allez-vous demander?
Question 3 Quel sera le traitement le plus approprié ?

Question 1 :
- Petite leucocytose, marquée principalement par une neutrophilie.
- Hémoglobine AUGMENTÉE. Mais microcytose. Donc microcytose sans anémie.
- Pas d’évidence d’infection, d’inflammation, de nécrose tissulaire, de médicaments (non pcq il change tt le temps et ça marche pas), pas de rate non fonctionnelle au frottis (hyposplénisme), pas d’hémolyse, pas vrm de désordre endocrinien, pas de grossesse. Donc on s’oriente pas mal vers soit une néoplasie ou une forme héréditaire (mais à un âge vieux pas le cas d’héréditaire).
- Éosinophiles élevés, mais pas d’allergie trouvée, pas de parasite dû à un voyage, pas de nouveaux médicaments.
- Basophiles élevés, mais pas d’hypothyroïde, pas de colite ulcéreuse, pas de varicelle.
- Diagnostique s’oriente vers : polycythémie vera.
- Prurit après la douche est typique de la polycythémie vera. Depuis 1 an donc lentement évolutif, c’est logique. La chute de vision pourrait être associé au fait que le sang est plus visqueux et plus épais, donc ne circule pas bien. Le faciès pléthorique est aussi expliqué par ça.
- EPO dépendante ou indépendante? Si indépendante néoplasie.
Question 2 :
- Bilan rénal et hépatique.
- Dosage d’EPO (on s’attend à ce qu’elle soit basse dans un cancer).
- Dosage de la ferritine (microcytose mais pas d’anémie, mais on veut juste vérifier).
- Recherche de la mutation JAK2 (si JAK2 négatif, on va voir CALR et MPL. Si encore négatif, aller voir t(9:22) pour s’assurer qu’on aurait pas manquer une LMC).
Question 3 :
- Phlébotomies (saignées). On prélève du sang jusqu’à ce que l’hématocrite diminue.
- Microcytose est dû au fait qu’on produit tlm de GR, mais pas de déficit en fer (on a pas besoin qu’ils soient aussi gros pcq on en a tlm bcp).
- Aspirine pour prévenir les complications thrombotiques.
- Si >60 ans ou ATCD thrombose : traitement oral chimiothérapie et/ou inhiteur de JAK2 si positif.

Madame Gauthier, une dame de 46 ans, doit subir une hystérectomie. Un bilan sanguin a été demandé en prévision de sa chirurgie. La formule sanguine est normale, incluant le décompte de plaquettes. Le coagulogramme de dépistage démontre un temps de saignement in vitro à 170 secondes (normale 60 à 105 secondes); un APTT à 36 secondes (normale 32 à 42 secondes); et un RNI à 1.1 (normale 0.93 à 1.15).
Question 1
Quelles sont 2 questions importantes à poser à cette patiente?
Question 2
Quels tests peuvent être effectués pour poursuivre l’investigation?
Question 1 :
- Histoire hémorragique?
- Prise d’aspirine ou AINS?
Question 2 :
- Étude de l’aggrégation plaquettaire.
- Étude du facteur de vW.
NB: le temps de saignement in vivo ou in vitro n’est pas une analyse à demander de routine. Intégré aux vignettes et APP à des fins pédagogiques
Alexandre, un garçon de 4 ans sans antécédent médical sauf un asthme léger, est amené à l’urgence pour épistaxis, bulles hémorragiques dans la bouche, pétéchies et purpura diffus, principalement aux membres inférieurs.
Question 1
Qu’évoque cet ensemble de signes et symptômes? Quel est le premier test que vous demanderez?
Question 1 :
- Évoque thrombocytopénie aiguë : thrombopénie auto-immune comme PTI (bulles hémorragiques).
- Leucémie aiguë possible aussi (bulles hémorragiques).
- Premier test à demander : FSC pour voir numération plaquettaire.
Madame Valicki, une dame de 40 ans, vous consulte pour fatigue progressive. L’histoire révèle des ménométrorragies de longue date. La formule sanguine démontre une hémoglobine à 80 g/L, avec un VGM à 65 fL et des plaquettes à 430 X 109/L. Le temps de saignement in vitro est allongé à plus de 250 secondes (normale 60 à 105 secondes), l’APTT est à 46 secondes (normale 32 à 42 secondes) et le RNI à 0.9 (normale 0.93 à 1.15).
Question 1
Quelle est le diagnostic le plus probable?
Question 2
Pourquoi l’APTT est-il allongé?
Question 1 :
- Maladie de vW type 1 et 2, à cause de l’APTT légèrement allongé, du temps de saignement in vitro allongé, des plaquettes normales.
- OU anémie ferriprive.
Question 2 :
- Le facteur VIII circulant est abaissé par diminution de sa protéine protectrice (le FvW).
Michaël, un garçon d’un an, vous est référé pour de grandes ecchymoses et un coude douloureux et enflé suite à un signalement à la Direction de la Protection de la Jeunesse. Son coagulogramme de dépistage démontre un APTT à 62 secondes (normale 32 à 42 secondes), et un RNI normal. Les plaquettes sont normales à la FSC.
Question 1
Quels sont les diagnostics les plus probables, par ordre de probabilité? Quel test faire rapidement devant un APTT allongé?
Question 1 :
- Avec un APTT allongé ça nous dit que c’est un problème de coagulation de la voie intrinsèque.
- Coude enflé et douloureux indique hémarthrose, ce qui indique aussi un problème de coagulation.
- Diagnostics possibles : Hémophilie A (VIII) ou B (IX).
- Probablement hémophilie A car 5 fois plus fréquente.
Quel test faire rapidement devant un APTT allongé?
- Répéter l’APTT sur un mélange 1:1 avec un plasma normal. On veut voir si on a un problème de facteurs ou d’inhibition des facteurs.
Monsieur Champagne, un homme de 42 ans, est admis pour hémorragie digestive secondaire à un ulcère gastrique. Il a déjà subi deux chirurgies dans le passé sans problème hémorragique. Son coagulogramme démontre un temps de céphaline à 112 secondes (normale 32 à 42 secondes) et un RNI à 1.0 (normale 0.93 à 1.15). Curieusement, même à l’époque de ses chirurgies passées, l’APTT était nettement allongé sans que cela semble avoir de conséquence clinique.
Question 1
Quel est le diagnostic que vous privilégiez?
Question 2
Quels tests complémentaires demanderez-vous?
Question 1 :
- C’est une des énigmes de la voie intrinsèque.
- Déficit en facteur XII.
- OU Déficit en facteur XI.
Question 2 :
- Répéter et faire mélange 1:1 avec plasma normal.
- Dosage des facteurs XII, XI, IX et VIII.
Discordance: APTT très allongé et absence de saignement avec chirurgie dans le passé;
Saignement sur une lésion pathologique (ulcère) peut survenir en l’absence de coagulopathie
Plus une question bonus, mais pas à l’examen
Monsieur Fortin, âgé de 52 ans, est admis d’urgence pour douleur aiguë à l’hypocondre droit avec fièvre et ictère sévère. Il est connu porteur de lithiases vésiculaires et consommation abusive d’alcool depuis de nombreuses années. Le coagulogramme demandé par l’urgentiste démontre un APTT normal et un RNI allongé à 2.1 (normale 0.93 à 1.15).
Question 1
Quelles peuvent-être les causes les plus probables de l’allongement du RNI?
Question 2
Comment peut-on améliorer l’hémostase en prévision d’une chirurgie?
Question 1 :
- Un déficit en facteur VII. Cela est le plus souvent dû à une déficience en vitamine K, qui viendrait des problèmes de foie du patient.
- Diminution des facteurs qui dépendent de la Vitamine K, par carence en vitamine K (le facteur VII étant le plus important parmi eux (impact négligeable sur les autres)).
– La vitamine K est liposoluble et mal absorbée en l’absence des sel biliaires qui ne rejoignent pas l’intestin lors de l’obstruction des voies biliaires (ictère).
Question 2 :
- Suppléments de vitamine K par voie parentérale ou transfusion de plasma.
Pierre Leblanc, un étudiant en médecine de 23 ans, présente une thrombose de la veine fémorale suite à un accident de ski et une immobilisation de quelques semaines. Il doit être anticoagulé durant 3 mois .
Question 1
Quel aurait été le plan thérapeutique recommandé il y a quelques années?
Question 2
Son grand frère, résident en médecine interne, suggère au médecin traitant d’instaurer plutôt un traitement avec un anticoagulant oral direct anti-Xa (tel le Rivaroxaban) d’emblée. En quoi ce traitement serait-il différent (avantages et désavantages)?
Question 1 :
- HBPM s/c pour 5-6 jours et début simultané de la warfarine po (avec monitoring).
Question 2 :
- Oui bonne option.
- Avantage : début du médicament oral d’emblée et sans monitoring.
Une patiente de 47 ans est dirigée à l’urgence suite à une visite à une clinique sans rendez-vous pour fatigue évoluant depuis les derniers 2 mois. Elle n’a pas d’antécédents médicaux si ce n’est que de 2 grossesses à terme dont le dernier remonte à il y a 15 ans et du reflux gastrique chronique. Elle prend du pantoprazole, un inhibiteur de la pompe à proton, quotidiennement pour ce problème. Ses règles sont, à ses dires, un peu irrégulières, soit aux 2 à 3 semaines, mais ne dure que 3 à 4 jours par cycle. Son examen physique, hormis une pâleur et une tachycardie exacerbée à l’effort, est sans anomalie.
À la formule sanguine, on note surtout une hémoglobine à 48 g/L.
Question 1
Si le VGM était à 60, quelles analyses supplémentaires voudraient vous faire préciser documenter l’étiologie la plus probable?
Question 2
Maintenant, imaginez que le VGM est à 120. Quels seraient vos réflexions alors?
Question 3
Pensez-vous qu’il y aurait lieu de transfuser la patiente en culots globulaires?
Question 1 :
- Bilan martial pour trouver l’étiologie microcytaire la plus probable (ferriprive, thalassémie, inflammation, sidéroblastique, intoxication au plomb).
Question 2 :
- Dosage B12 et folate.
- RÉTICULOCYTOSE? HÉMOLYSE (RÉTICULOCYTES À VOIR)? MALADIES HÉPATIQUES? MÉTABOLIQUES (Hypothyroïdie)?.
Question 3 :
- Raisonnable car hémoglobine en bas de 70 (MAIS PAS UNE OBLIGATION). Dépend de notre jugement clinique et des risques de la patiente. Elle est encore jeune donc cela est à son avantage.
Un homme de 67 ans est récemment diagnostiqué avec un lymphome non Hodgkinien du centre folliculaire, diffus à grandes cellules (c.à.d. de grade intermédiaire), Stade IIB il y a 2 semaines. Après une évaluation soigneuse, il a reçu son premier cycle de R-CHOP il y a 8 jours. Il est ramené en clinique externe ce matin par son conjoint puisque depuis la veille il se sent plus faible, et vient de frissonner à la maison de façon incontrôlable. À l’arrivée, il est de plus en plus obnubilé, et sa tension artérielle est de 90/40 avec un pouls à 110/minutes. Il y a des ecchymoses multiples aux bras, et des phlyctènes hémorragiques à la bouche. On entend des râles au sommet droit avec un souffle tubaire (signe potentiel de bronchopneumonie).
Sa formule sanguine, normale il y a 1 semaine au moment de l’administration de sa chimiothérapie, indique les éléments suivants :
GB (Leucocytes) : 0.3 x 109/L
Hb (Hémoglobine) : 93 g/L
VGM : 94fL
Plt (Plaquettes) : 14 x 109/L
Différentielle automatisée :
Neutrophiles : 0.2
Lymphocytes : 0.0
Monocytes : 0.1
Éosinophiles : 0.0
Basophiles : 0.0
Question 1
Comment caractériseriez-vous cette formule sanguine?
Question 2
Est-ce que ce patient mérite une thérapie transfusionnelle quelconque? Si oui, laquelle?
Bonus
Bonus : Quels autres éléments cliniques pouvez-vous identifier qui nécessitent votre attention immédiate?
Question 1 :
- Pancytopénie assez évidente (chimiothérapie récente cause un nadir 7-10 jours, qui peut donner un choc probablement septique à la pneumonie).
Question 2 :
- Plaquettes pourraient être nécessaires, car elles sont vrm basse (rappel : 1 dose de plaquettes = 5U).
- Culot globulaire non nécessaire.
- Gammaglobulines intraveineuses non nécessaires.

Une patiente de 23 ans arrive à l’urgence après avoir remarqué sur ses jambes de nombreux picots rouges s’étendant surtout des genoux aux chevilles ainsi qu’aux points de pression autour de sa taille et de sa région thoracique. Elle n’a aucun antécédent médical. Plusieurs de ses amis de l’université ont eu une sorte de grippe dans les dernières semaines. Sauf une journée un peu plus pénible pendant la semaine dernière où elle a été obligée de manquer ses cours un après-midi pour céphalée, elle se sent relativement bien.
Son examen physique est conforme bien que vous vous demandez s’il y a avait une pointe de rate à l’inspiration profonde lorsque vous palpez l’hypocondre gauche. Elle a quelques petites adénopathies cervicales et sus claviculaires.
À la formule sanguine, on rapporte les faits suivants :
GB (Leucocytes) : 3.0 x 109/L
Hb (Hémoglobine): 115 g/L
VGM: 82 fL
Plt (Plaquettes) : 4 x 109/L
Différentielle manuel :
Neutrophiles: 10%
Stabs (Bands): 13%
Lymphocytes : 50%
Lymphocytes atypiques : 20%
Monocytes : 5%
Éosinophiles : 1%
Basophiles : 1%
Question 1
En priorité de sévérité, quels sont les anomalies que vous voudrez signaler ?
Question 2
Quel est votre hypothèse diagnostique de travail?
Question 3
Feriez-vous appel à la banque de sang pour des plaquettes, ou pour tous autres produits?
Question 1 :
- Thrombopénie sévère et isolée.
- DIFFÉRENTIELLE LEUCOCYTAIRE: SUGGESTIVE D’UNE VIRÉMIE
RÉCENTE (▪ INVERSION DU LEUCOGRAMME ▪ NEUTROPHILES ET STABS LIMITES ▪ LYMPHOCYTOSE AVEC LYMPHOCYTES ATYPIQUES ▪ QUELQUES MONOCYTES).
Question 2 :
- PTI (probablement secondaire dû au manque d’indices primaires).
Question 3 :
- Transfusion de plaquettes serait peu efficace (pcq ses anticorps les détruisent).
- Immunosuppression serait probablement une meilleure option (corticostéroïdes en priorité ou rituximab).
- Immunoglobulines IV pourrait aider.
- Analogues de la TPO pourrait aider pour fabriquer plus de plaquettes.
- Donner certains facteurs de coagulation aussi.
Un homme de 44 ans se présente pour une vérification de routine à la clinique d’anticoagulothérapie, puisqu’il prend du Coumadin suite à une récidive d’embolie pulmonaire. Il a toujours été stable avec INR thérapeutique désirée (2.0-3.0) sous dosage de 7.5 mg po die. Son dernier INR remonte à 6 semaines. Il prend aussi 80 mg d’ASA die tel que prescrit par son cardiologue.
Ce jour son résultat revient à un niveau de 6.3.
Le patient est ambulatoire, il n’y a pas d’évidence d’hémorragie.
Question 1
Quels sont les questions clefs à poser dans ce cas?
Le patient refuse de rester dans le couloir de la salle d’urgence suite à discussion informée. Vous lui faites administrer sur place 1 mg de vitamine K po, et vous le laissez partir avec la consigne de se représenter d’urgence s’il y avait hémorragie au courant des prochaines heures et jours. Un rendez-vous de relance est inscrit pour le début de la semaine prochaine.
Le choix est malheureux. Pendant la nuit, le patient est amené en ambulance à la salle d’urgence puisqu’il est étourdi lorsqu’il se lève, et depuis peu, il a des selles noires. On le retrouve hypotendu à son triage - il passe en priorité 1 (pas d’attente de 18 heures dans ce cas).
Suite à une stabilisation de sa tension artérielle avec administration de solutés appropriés, on obtient les analyses suivantes :
GB (Leucocytes) : 10.9 x 109/L
Hb (Hémoglobine) : 93 g/L
VGM : 97fL
Plt (Plaquettes) : 240 x 109/L
INR : 4.2
Différentielle automatisée :
Neutrophiles : 9.0
Lymphocytes : 1.2
Monocytes : 0.5
Éosinophiles : 0.2
Basophiles : 0.0
Question 2
Quelles anomalies voyez-vous à ces résultats, et quels seraient les éléments d’intervention que vous considèreriez?
Question 3
S’il y avait une hémorragie cérébrale au lieu d’une hémorragie digestive, changeriez-vous vos recommandations thérapeutiques hématologiques?
Analyse :
- Pt reçoit anti-vitamine K (Warfarin).
- ATCD thrombose et contexte de thrombophilie.
-
Question 1 :
- Est-ce que vous prenez des médicaments? (ALTÈRE LA DISPONIBILITÉ DE LA VITAMINE K INTESTINALE ▪ PEUT ALTÉRER LE TRANSPORT DES RX ANTI-VITAMINE K).
- Avez-vous récemment changé vos médicaments? (PEUT ALTÉRER LE TRANSPORT DES RX ANTI-VITAMINE K).
- Avez-vous récemment modifié votre alimentation? (▪ LÉGUMES, FRUITS (SOURCES DE VITAMINE K) ▪ ALCOOL (REMPLACE AUTRES ALIMENTS…) ▪ DIÈTES, CHIMIOTHÉRAPIE, …)
Question 2 :
- Certains profils d’inflammation : neutrophiles à la limite supérieure et lymphocytes un peu diminués.
- Anémie modérée : mais on a une composante dilutionnelle possible, et l’installation semble normale considérant l’Hb de la veille à 150 g/L.
- INR : un peu mieux, mais encore du chemin à faire pour l’améliorer.
- Dans tous les cas, il faudrait : transfuser un culot globulaire si évidence d’hémorragie continue (choc hémorragique), transfuser du plasma ou cryoprécipité pour remplacer les facteurs de coagulation et ainsi améliorer l’INR, demander une gastroscopie pour documenter le site de l’hémorragie (rappel : méléna est associé à une hémorragie digestive haute).
- Si instable, transférer aux soins intensifs.
Question 3 :
- CONCENTRÉ DE COMPLEXE PROTHROMBINIQUE (BERIPLEX / OCTAPLEX).
- CONCENTRÉDEFACTEURSII,VII,IX,X
▪ Disponible à la Banque de Sang.
RÉSERVÉ POUR LES URGENCES
ADMINISTRATION EN 15 MINUTES (VS > 1 HEURE PLASMA) CORRECTION COMPLÈTE DE L’INR
- Mais temporaire: 6-8 heures sans vitamine K… RISQUE THROMBOTIQUE POSSIBLE…
























